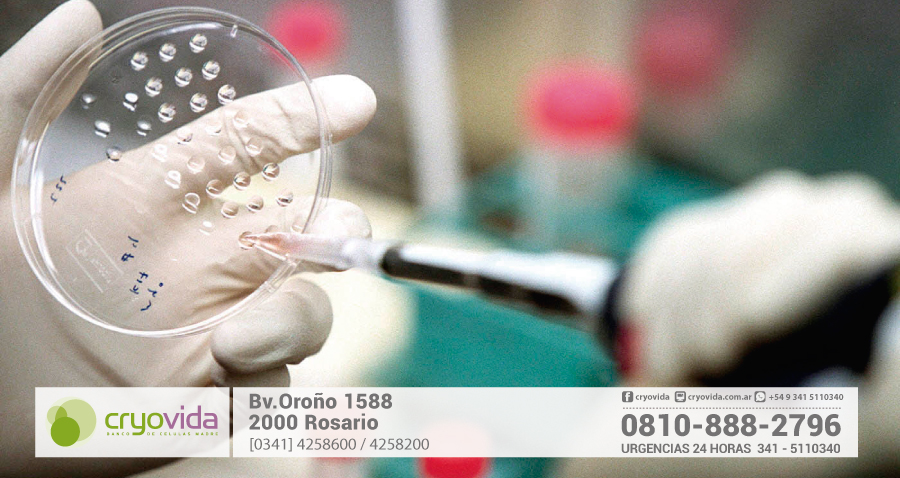
Tratan con células madre a nena con labio leporino

Tratan con células madre a nena con labio leporino

Pilates para embarazadas: Ejercicios, recomendaciones y contraindicaciones
3 agosto, 2017
¿Cómo no ser una madre perfecta?
3 agosto, 2017Según afirman los médicos, se mejoraron notablemente los niveles de cicatrización en el paladar, por lo que la menor se recupera favorablemente
Una niña argentina que nació con labio leporino está siendo tratada con células madre y según afirman los médicos, se mejoraron notablemente los niveles de cicatrización en el paladar, por lo que el cuadro evoluciona. La menor, llamada Francesca, se recupera ahora de su labio leporino bilateral a partir de un innovador tratamiento realizado sobre la base de las células extraídas de su propio cordón umbilical al momento de nacer.
En la Argentina, cerca de 60.000 familias ya eligieron preservar las células madres del cordón umbilical al momento de tener un hijo para eventuales tratamientos futuros y nuevos descubrimientos sobre los que pueda avanzar la ciencia. Si bien se recomienda tomar la decisión en el segundo trimestre del embarazo -ya que luego se puede adelantar el parto corriendo el riesgo de no tener todo organizado- es importante recalcar que los Bancos de Células Madre cuentan con servicios de urgencia, en caso que la madre no llegara a realizar los trámites con anterioridad.
En la actualidad, los tratamientos con células madre ofrecen una alternativa que permite al cuerpo la auto regeneración y son cada vez más las investigaciones científicas que ya las utilizan en terapias experimentales para reparación del músculo cardíaco, cirugía ortopédica, odontología, enfermedades autoinmunes y hasta enfermedades neurológicas.
Hace aproximadamente una década se comenzó a criopreservar sangre de cordón en forma privada en Argentina, lo que permite que el donante pueda utilizar sus propias células para tratamientos personalizados y 100% compatibles.
En la actualidad, existen en la Argentina unos siete bancos privados -cuatro en la Ciudad de Buenos Aires, uno en Córdoba, uno en Rosario y otro en Mar del Plata- que ofrecen este servicio de conservación. Así se desprende de la Asociación de Bancos de Células Madre ABC Cordón- una asociación sin ánimos de lucro que busca concientizar a la población en general sobre la importancia de conservar las células de cordón umbilical para uso personal o donación.
Un caso que da esperanza
Andrés y Valeria vivieron hace pocos meses una situación inesperada y decidieron contar la historia de cómo llegaron al tratamiento de Francesca, su hija nacida con labio leporino que ahora evoluciona.
«Con mi esposa necesitamos un tratamiento de fertilización in vitro para poder ser papás. Cerca de los 4 meses de gestación, nos enteramos de que Francesca tenía labio leporino bilateral con fisura de paladar completo», relatan.
Fue en ese momento que el obstetra de la pareja, el doctor Sebastián Neuspiller, recomendó a Andrés y Valeria guardar las células madre de cordón para un posible tratamiento post nacimiento.
Así fue como llegaron al doctor Guillermo Trigo, el especialista argentino que realizó en 2009 la primera operación mundial de labio leporino con células madre. Allí conocieron el procedimiento y se les explicaron los alcances del tratamiento autológico: en el punto más bajo era inocuo -por lo que no perjudicaba la salud de Francesca- y en el más alto podían esperar una amplia regeneración ósea, pudiendo evitar alguna de las tantas operaciones que tendrá que realizarse la nena en el transcurso de su vida.
«Organizamos todo para que el día del parto se pudieran recolectar las células. Antes del año de vida ya estábamos encaminados para avanzar con la primera intervención, en la que se aplicaron células madre en el paladar blando y duro», cuentan los padres. Y agregan: «El tratamiento autológico está en curso y tenemos una excelente perspectiva de la cicatrización, tanto a nivel salud como estético».